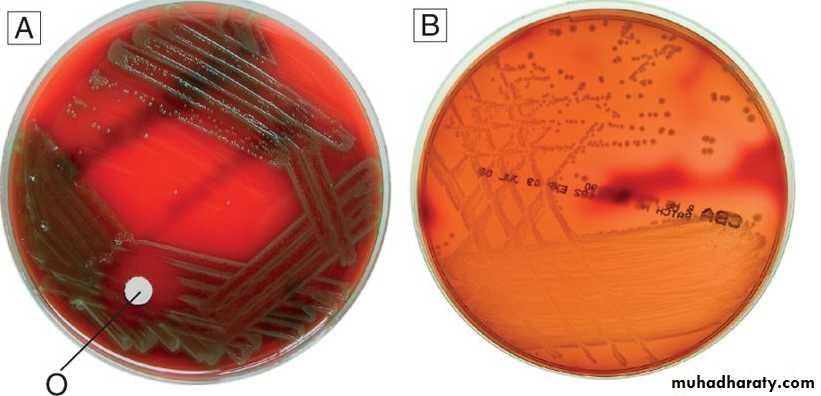

Medical terminologylecture 1
Dr. Ali Al-ZaidyCABM
(MEDICINE)
Some combining forms that are condition or condition-related include:
Some combining forms that refer to position or location include:
Medical terminologylecture 2
Dr. Ali Al-ZaidyCABM (MEDICINE)